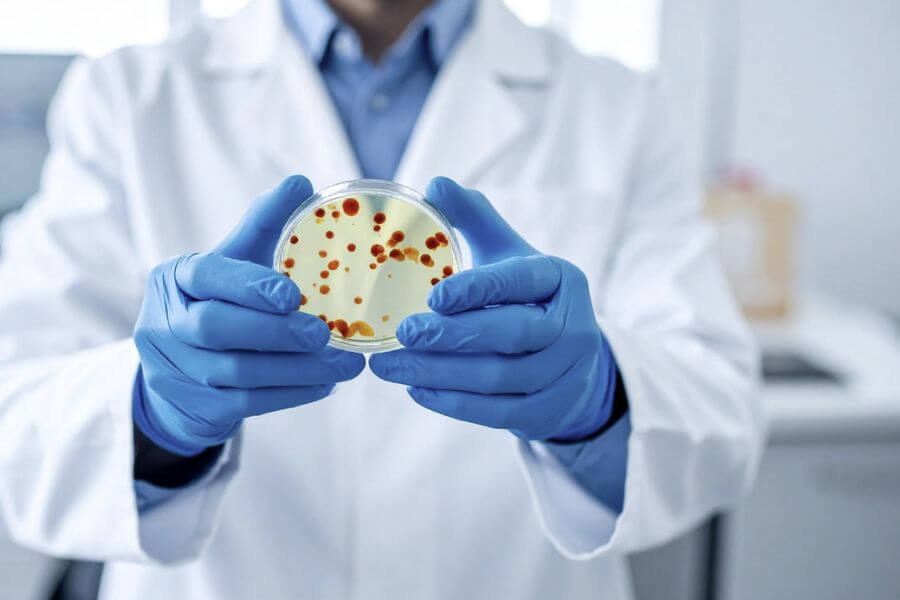
세균막(바이오필름), 전문 살균제가 필요한 환경과 일상 관리로 충분한 공간의 경계를 고민하게 된 이유

📑 목차
세균막(바이오필름) 전문 살균제가 필요한 환경과 일상 관리로 충분한 공간의 경계를 구조적으로 설명합니다. 문지르고 닦는 청소의 한계와 치아·의료기기 사례를 일상 위생 기준으로 재해석한 경험 기반 글입니다.
세균막(바이오필름)이 전문 살균제가 필요한 환경과, 문지르고 닦는 일상 관리만으로 충분한 공간의 경계는 생각보다 명확하지 않았다. 필자는 오랫동안 “열심히 닦으면 해결된다”는 기준으로 위생 관리를 해왔다. 하지만 아무리 문지르고 닦아도 반복되는 찝찝함과 불쾌감은 그 기준이 완전하지 않다는 사실을 계속해서 드러냈다. 이 과정에서 필자는 세균막(바이오필름)을 단순한 오염 문제가 아니라, 환경과 구조에 따라 관리 방식이 달라져야 하는 현상으로 인식하게 되었다.
특히 치아나 의료기기처럼 자주 세균막 사례로 언급되는 대상들을 접하며, 필자는 이를 의료적 위험이 아닌 일상 위생 기준을 이해하기 위한 구조적 예시로 다시 바라보게 되었다.
발생 원인 →문지르고 닦는 청소가 기준이 되었던 과거의 위생 인식
필자가 세균막(바이오필름) 구조를 인식하기 전까지의 위생 기준은 매우 단순했다. 찝찝함이 느껴지면 더 자주 닦고, 더 세게 문지르면 해결될 것이라 믿었다. 눈에 보이는 오염이 사라지는 순간, 문제 역시 함께 해결되었다고 판단했다. 실제로 청소 직후의 환경은 깔끔해 보였고, 겉으로 드러나는 불쾌 요소도 잠시 사라졌다. 그때마다 필자는 자신의 관리 방식이 충분히 효과적이라고 생각했다.
하지만 문제는 항상 시간이 지난 뒤에 다시 나타났다. 청소를 한 지 하루, 혹은 몇 시간이 지나지 않아 같은 자리에서 동일한 찝찝함이 반복되었다. 특히 손이 자주 닿는 부위나 수분이 개입되는 환경에서는 이런 현상이 훨씬 빠르게 재현되었다. 분명히 닦았고, 분명히 정리했음에도 불구하고 불쾌감은 사라지지 않았다. 이 반복은 점점 필자를 혼란스럽게 만들었다.
이러한 실패가 누적되면서, 필자는 처음으로 “내가 놓치고 있는 기준이 있는 건 아닐까”라는 의문을 갖게 되었다. 단순히 덜 닦아서가 아니라, 문지르고 닦는 청소 방식 자체가 해결할 수 없는 영역이 존재하는 것처럼 느껴졌다. 그동안 당연하게 여겨왔던 위생 인식이 흔들리기 시작했고, 이 균열이 바로 세균막(바이오필름)을 구조적으로 바라보게 된 출발점이었다.
구조 설명 →세균막(바이오필름)이 문지르고 닦는 청소를 무력화하는 이유
세균막(바이오필름)의 구조를 이해하면서, 필자의 위생 인식은 근본적으로 바뀌었다. 세균막은 단순히 세균이 표면에 묻어 있는 상태가 아니었다. 세균이 표면에 부착한 뒤, 스스로를 보호하기 위해 점액질 보호막을 형성하고 그 안에서 집단을 이루며 살아가는 구조였다. 이 보호막은 외부 자극을 차단하고, 물리적인 마찰에도 쉽게 무너지지 않는 특성을 가진다.
이 구조를 알게 되자, 문지르고 닦는 청소가 왜 반복적으로 실패했는지가 명확해졌다. 표면을 아무리 깨끗하게 닦아도, 세균막은 미세한 틈이나 요철, 눈에 보이지 않는 구조 안쪽에 남아 다시 활성화된다. 특히 수분, 유기물, 손의 유분이 반복적으로 공급되는 환경에서는 세균막이 제거되기보다 오히려 안정화되는 조건이 만들어진다.
필자가 경험했던 “청소 직후에는 괜찮다가 다시 찝찝해지는 현상”은 바로 이 구조적 특성의 결과였다. 이는 청소가 부족해서가 아니라, 청소 방식이 세균막의 구조를 고려하지 않았기 때문에 발생한 문제였다. 이 이해를 통해 필자는 세균막(바이오필름) 전문 살균제가 필요한 환경과, 일상 관리로 충분한 공간의 경계가 단순한 노력의 문제가 아니라 구조의 문제라는 사실을 분명히 인식하게 되었다.
실제 사례 →치아·의료기기 사례를 일상 위생 기준으로 재해석하며 느낀 한계
치아나 의료기기는 세균막(바이오필름)의 대표적인 사례로 자주 언급된다. 필자는 이 사례들을 치료나 의료적 위험의 관점이 아니라, 세균막이 유지되기 쉬운 구조를 설명하는 예시로 다시 바라보게 되었다. 치아 표면은 작고 복잡하며, 수분과 유기물이 지속적으로 공급된다. 아무리 관리해도 시간이 지나면 다시 관리가 필요한 이유는 구조 자체에 있었다.
의료기기 역시 마찬가지다. 내부 구조가 복잡하고, 완전한 건조가 어렵기 때문에 단순한 세척만으로는 관리가 충분하지 않은 경우가 많다. 이 두 사례를 일상으로 확장해 보니, 필자가 반복적으로 문제를 겪던 환경과 매우 닮아 있다는 사실이 눈에 들어왔다. 겉보기에는 깨끗하지만, 구조적으로 세균막이 유지되기 쉬운 조건이 반복되는 공간들이었다.
이 경험을 통해 필자는 깨달았다. 어떤 환경은 일상적인 관리로 충분하지만, 어떤 환경은 구조적으로 관리 기준을 달리해야 한다는 사실을 말이다. 전문 살균 관리가 필요한 환경과 일상 관리로 충분한 공간을 구분하지 않으면, 문지르고 닦는 청소는 계속해서 같은 실패를 반복할 수밖에 없다는 점을 체감하게 되었다.
증상 정리 →구조적 문제가 드러내는 세균막(바이오필름)의 신호들
세균막(바이오필름)이 문지르고 닦는 청소로 해결되지 않을 때, 그 신호는 매우 일정한 형태로 나타났다. 가장 먼저 눈에 띈 변화는 촉감이었다. 표면은 깨끗해 보였지만, 손으로 만졌을 때 미묘한 미끄러움이나 잔여감이 느껴졌다. 이 감각은 즉각적으로 강하지는 않았지만, 반복될수록 분명해졌다.
두 번째 신호는 시간차 재현이었다. 청소 직후에는 문제가 사라진 것처럼 보이다가, 일정 시간이 지나면 동일한 불쾌감이 다시 나타났다. 이 패턴은 거의 예외 없이 반복되었고, 단순한 오염이나 관리 부족으로는 설명하기 어려운 특징을 가지고 있었다. 이는 세균막이 완전히 제거되지 않은 상태에서 다시 활성화되고 있다는 신호처럼 느껴졌다.
마지막으로 나타난 것은 심리적인 위생 불안감이었다. 특정 환경을 사용한 뒤 손을 씻고 싶어지는 충동, 다시 닦고 싶어지는 생각은 점점 더 잦아졌다. 이전에는 이를 예민함으로 넘겼지만, 구조를 이해한 이후에는 이 감각이 환경이 보내는 경고라는 사실을 받아들이게 되었다. 결국 찝찝함은 기분의 문제가 아니라, 세균막(바이오 필름) 구조가 여전히 유지되고 있다는 명확한 신호였다.
결론 →세균막(바이오필름) 관리의 기준을 구조로 옮기다
최종적으로 필자가 내린 결론은 매우 분명했다. 세균막(바이오필름)에 있어 전문 살균제가 필요한 환경과, 일상적인 관리만으로도 충분히 유지 가능한 공간의 경계는 단순히 얼마나 열심히 닦았는가에 달려 있지 않았다. 그 경계는 오히려 구조적으로 관리가 가능한 환경인가, 그리고 세균막이 형성되고 유지될 조건이 반복되는 구조인가에 의해 결정된다는 사실이었다. 문지르고 닦는 청소는 위생 관리의 기본이지만, 모든 환경에 동일하게 적용할 수 있는 만능 해결책은 아니었다. 이 사실을 인식하지 못한 채 청소 강도만 높여왔던 과거의 방식은, 결국 같은 실패를 반복하게 만들 뿐이었다.
이 인식 이후 필자는 위생 관리의 방향을 근본적으로 수정했다. 더 세게 닦고, 더 자주 문지르는 방식에서 벗어나, 세균막이 유지될 수 있는 조건 자체를 하나씩 점검하기 시작했다. 수분이 남아 있는 구조는 없는지, 완전한 건조가 가능한 환경인지, 접촉이 반복되면서 유기물이 계속 공급되는 위치는 어디인지, 그리고 사용 기간이 누적되며 구조적 변화가 생긴 물건은 무엇인지 등을 기준으로 삼았다. 청소는 여전히 필요했지만, 그보다 중요한 것은 세균막이 다시 살아날 수 있는 여지를 남기지 않는 관리였다. 필자는 세균막(바이오 필름)을 이해한 후 관리 또한 편해졌다.
완전한 건조는 그중에서도 가장 중요한 기준이 되었다. 닦은 뒤 바로 덮어두거나, 자연스럽게 마를 것이라 넘겼던 습관은 점차 사라졌다. 접촉 빈도가 높은 부위는 무작정 자주 닦는 대신, 관리 방식 자체를 단순화하거나 구조를 바꾸는 쪽으로 접근했다. 또한 사용 기간이 오래된 물건에 대해서는 “아직 쓸 수 있는가”보다 “세균막이 축적되기 쉬운 상태는 아닌가”를 먼저 판단하게 되었다. 이러한 기준 변화는 위생 관리에 대한 피로감을 줄이는 데에도 큰 역할을 했다.
그 결과는 분명했다. 이전처럼 이유 없이 반복되던 찝찝함은 점점 줄어들었고, 관리에 대한 불신도 함께 사라졌다. 무엇보다 “이렇게까지 했는데도 왜 안 되지?”라는 무력감에서 벗어날 수 있었다. 지금의 필자에게 세균막(바이오필름)은 막연히 두려워하거나 과도하게 경계해야 할 대상이 아니다. 대신, 어떤 환경에서는 일상 관리로 충분하고, 어떤 환경에서는 구조적으로 다른 대응이 필요하다는 것을 구분해야 할 위생 구조로 인식되고 있다.
이 글은 세균막을 제거하는 방법을 나열하기 위한 기록이 아니다. 문지르고 닦는 청소가 실패로 돌아갔던 이유를 되짚고, 전문 살균제가 필요한 환경과 그렇지 않은 공간의 경계를 체감으로 정리한 하나의 경험 기록이다. 필자는 이 구분을 알게 된 이후에야 비로소, 위생 관리가 불안과 피로의 영역이 아니라 예측 가능한 생활 관리의 영역으로 들어왔음을 느끼고 있다.
'세균막(바이오필름)' 카테고리의 다른 글
| 아침마다 반복되던 치아 표면의 이질감, 세균막(바이오필름)으로 설명되다 (0) | 2025.12.31 |
|---|---|
| 양치 직후엔 괜찮은데 금방 다시 찝찝해졌던 이유, 세균막(바이오필름) 때문이었다 (0) | 2025.12.30 |
| 물리적 청소만으로는 부족했던 이유, 세균막(바이오필름) 구조를 알게 되다 (0) | 2025.12.30 |
| 세균막(바이오 필름)에 대한 위생 기록이 습관이 되기까지의 시작 (0) | 2025.12.27 |
| 세균막(바이오필름)으로 인한 일상의 찝찝함을 기록하기 시작한 계기 (0) | 2025.12.26 |



